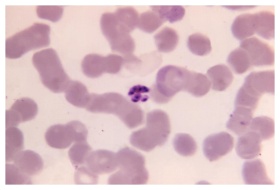

AI Retouch
Mini editor
✨ Touch up this photo without leaving the page
Use the inline editor for quick tweaks, or jump into the full Image Studio for advanced controls and a complete creative experience.
A 1125X photomicrograph magnification of a Giemsa
A 1125X photomicrograph magnification of a Giemsa stained, thin film blood smear, revealed a mature, Plasmodium malariae schizont. Original image sourced from US Government department: Public Health Image Library, Centers for Disease Control and Prevention. Under US law this image is copyright free, please credit the government department whenever you can”.
Similar Photos
A modern minimalist house exterior, featuring a sl
by Prof. Lisette Reichel

A conceptual 3D rendering of a blue geometric stru
by Gerald Bashirian V

3D render of two yellow cartoon fists facing each
by Maci Jerde Jr.

Artistic still life featuring geometric shapes and
by Barton Schneider DDS

Abstract art installation featuring moss and futur
by Dr. Pascale Stiedemann DDS

A minimalist abstract blue background with a light
by Loy Altenwerth

NASA Marshall Advances 3-D Printed Rocket Engine N
by Abigayle Rodriguez

Man riding bicycle clipart, lifestyle
by Dr. Eliezer Effertz

Man riding bicycle clipart, lifestyle
by Dr. Eric Hickle MD

Man riding bicycle clipart, lifestyle
by Prof. Rick Rippin

Odell Kassulke
117 Photos
-
3
-
0
-
0
License and Use
Free for commercial use No attribution required- Details
- Photo #67296
- Published on Nov 19, 2025
- Photo type JPG
- Resolution 1248x848
- Category 3D
- Subcategory Algae
- File size 109.8kB